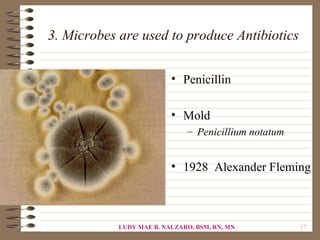
3. Microbes are used to produce Antibiotics


                          • Penicillin

                          • Mold
                              – Penicillium notatum


                          • 1928 Alexander Fleming



            LUDY MAE B. NALZARO, BSM, RN, MN          17

This document provides an overview of microbiology and microorganisms. It defines key microbiology terms like colony, prokaryotes, eukaryotes, algae, bacteria, and saprophytes. It discusses the history of microbiology including early pioneers like Anton van Leeuwenhoek, Louis Pasteur, and Robert Koch. It also explains taxonomy and the five kingdoms of life. Overall, the document serves as an introduction to the field of microbiology.